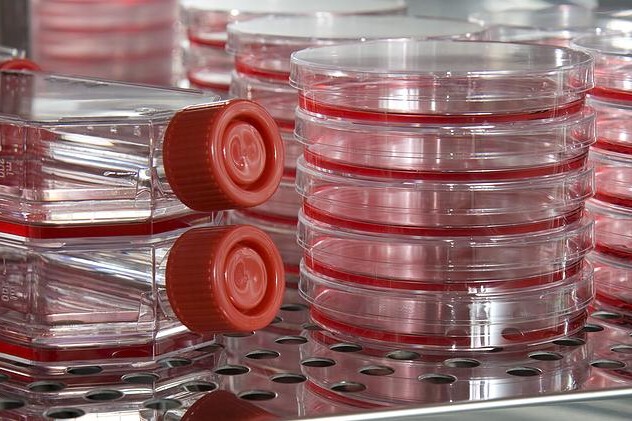
Jak HPV působí na buňky a jak je mění

Dehydratace je nedostatek tekutin v těle. Ohrožuje především děti a staré lidi.

V dnešní době je identifikováno přes 100 typů HPV virů. HPV viry můžeme rozdělit na ty, které vytvářejí změny na genitálu, ve smyslu rakoviny, a na ty, které způsobují jen bradavice. HPV virus má schopnost zabudovat se do buňky a ovlivňovat v ní určité buněčné pochody, např. vyvolat extrémní buněčné dělení, čímž dává za vznik rakovině děložního čípku.
HPV je anglická zkratka pro Human Papilloma Virus, česky lidský papilomavirus. Patří mezi DNA viry a je přenosný pohlavní cestou. Infekce HPV, která je bezpříznaková, vede ve výsledku ke vzniku karcinomu děložního čípku. Toho jsou schopné určité typy virů, říká se jim vysoce rizikové. Existují i nízce rizikové typy, které způsobují méně nebezpečné změny na genitálu, bradavice. Je známo, že infekce postihuje tu část populace, která žije pohlavním životem. Velká většina žen, udává se 80%, se za svého života s HPV infekcí setká. Organismus se ve většině případů s infekcí vyrovná a virus zneškodní, bohužel ale existuje možnost opětovného nakažení.
V dnešní době je identifikováno přes 100 typů HPV a z toho asi 30 typů způsobuje změny na genitálu. Dělí se podle potenciálu vyvolávat zhoubný nádor, a to na vysoce rizikové HPV, které jsou zodpovědné za vznik karcinomu děložního čípku, hlavně typy 16 a 18 a nízce rizikové HPV, které vyvolávají bradavice, hlavně typy 6 a 11. HPV. Stejně jako všechny jiné viry, potřebují i tyto ke svému životu a rozmnožování buňky lidského organismu. Mají schopnost se navázat na povrch buněk sliznice a kůže, proniknout dovnitř a zabudovat se do lidské DNA, nositelky genetické informace. Za normálních okolností je rozmnožování buněk lidského těla pod kontrolou organismu, ale HPV vyvolávají ztrátu kontroly množení buněk, které se pak neřízeně množí. Současně HPV virus ovlivňuje v buňce určité mechanismy a vznikají charakteristické změny buněk a hlavně jejich jader, tzv. atypie, které jsou známkou zhoubnosti a které „zdravé" buňky nemají. Atypie jsou rozhodujícím poznávacím znamením při mikroskopickém hodnocení. Vysoce rizikové typy HPV tedy mají schopnost navodit zhoubný zvrat buněk sliznice genitálu.
Výše uvedené atypie jsou základním kritériem pro vyhodnocování onkologické cytologie, při níž se odebírá stěr z čípku při gynekologické prohlídce. Při stěru se na štětičku zachycují buňky a tento materiál je pak vyhodnocován pod mikroskopem, kde se hledají atypické buňky. Atypické buňky mají zvětšené a nepravidelné jádro, buňky mají různé rozměry a jsou přítomny i další změny, díky kterým patolog odliší tyto zhoubně změněné buňky od normálních. Zpočátku tyto změny nejsou příliš velké a označují se jako prekancerózy, ze kterých v průběhu let může vzniknout zhoubný nádor, když se nezachytí včas a nezačne se s adekvátní léčbou. Prekancerózy se označují jako skvamózní intraepitelové léze (SIL), které mohou být nízkého stupně, vyžadující pouze kontroly a existuje možnost jejich odeznění, a vysokého stupně, které je nutné odstranit, protože u těchto jsou buněčné změny již pokročilé a je velké nebezpečí vzniku karcinomu děložního čípku. Zda infekce HPV povede ke vzniku prekanceróz nebo ne, ovlivňují i další faktory, mezi něž patří sexuální promiskuita, časný začátek sexuálního života, časný věk prvního těhotenství, špatný stav obranyschopnosti nebo kouření.
Jelikož je infekce HPV viry v populaci velmi častá, je třeba zamezit působení rizikových faktorů. Udává se, že ani bariérový typ antikoncepce jako je kondom, není schopen zabránit přenosu, protože HPV se přenáší i kontaktem s kůží infikovaného. Kromě sexuální zdrženlivosti je další metodou prevence očkování. Očkování je nejúčinnější u dívek 9 – 13 let, které ještě nezačali se sexuálním životem. Navíc od dubna 2012 třináctiletým dívkám hradí očkování zdravotní pojišťovny. Očkování mohou podstoupit i chlapci do 15 let, kteří mohou být přenašeči HPV viru a očkování je může uchránit před rakovinou penisu a konečníku. Očkování se provádí ve třech dávkách do ramenního svalu. Avšak i u sexuálně žijících žen bez věkového omezení má očkování proti HPV viru význam. Důležité je ale posoudit individuální riziko získání nové HPV infekce. Je nutné mít na paměti, že očkování je účinné pouze na ty nejčastější typy HPV viru, a že i přes očkování se může rakovina děložního čípku objevit. Nejdůležitější tedy zůstávají pravidelné gynekologické prohlídky.